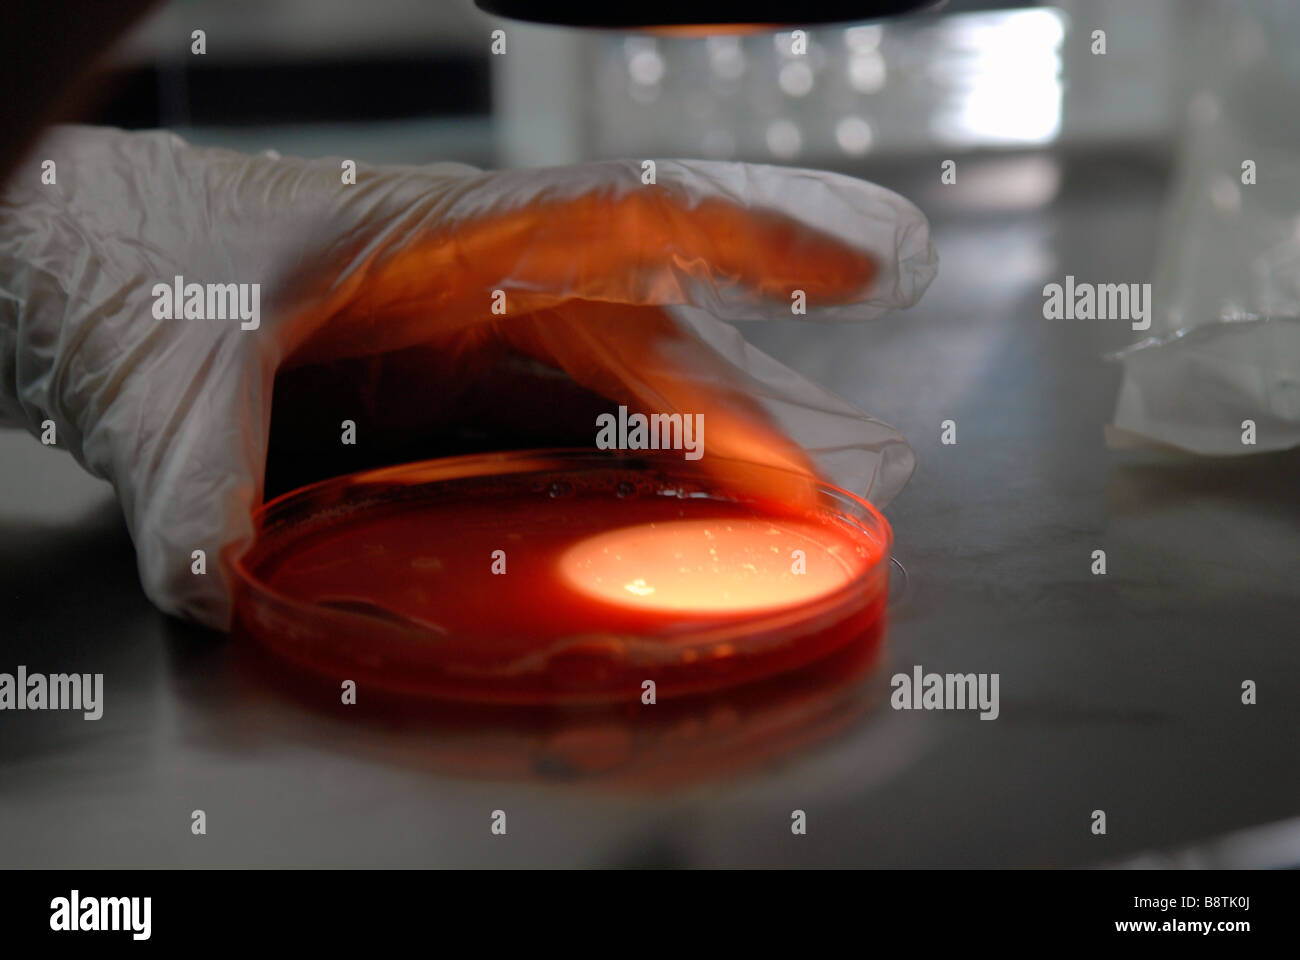
Embryologe Inverkehrbringen Embryo auf einer Kulturschale während der vitrifikation Prozess an der Klinik in Sheba Medical Center in Tel Hashomer, Israel Stockfoto

Sheba medizinisches zentrum Stockfotos & Bilder
(515)sheba medizinisches zentrum-Stockvideoclips ansehenSchnellfilter:
Sheba medizinisches zentrum Stockfotos & Bilder

RMADBJEM–Embryologe Inspektion Ultra sound Screenshot an der Klinik in Sheba Medical Center, Tel Hashomer, Israel

RM2B087FW–Ramat Gan, Israel. Feb. 2020. Der israelische Professor Galia Rahavm, Leiter der Infektionskrankheiten, zeigt einen Isolationsraum, da der israelische Premierminister Benjamin Netanyahu am Mittwoch, 19. Februar 2020, das Chaim Sheba Medical Center für eine Diskussion über das Coronavirus in Tel Hashomer in Ramat Gan, Israel, aufführt. Das israelische Gesundheitssystem bereitet sich auf den möglichen Ausbruch eines Coronavirus vor. Foto von Foto von Heidi Levine/UPI Credit: UPI/Alamy Live News

RMDPCN40–Sderot, Israel, 12. Januar 2014. Arbeiter bereiten das Grab für Ariel Sharon in Südisrael Havat Hashikmim, außen Sderot, am 12. Januar 2014. Der ehemalige israelische Ministerpräsident Ariel Scharon starb am Samstag im Alter von 85, der Direktor der Rehabilitationsklinik an der Sheba Medical Center, die Shlomo Noy auf einer Pressekonferenz im Krankenhaus bestätigt. (Xinhua)

RM2GACNCX–Ramat Gan, Israel. Juli 2021. Der israelische Präsident Isaac Herzog spricht mit Journalisten, bevor er am Freitag, den 30. Juli 2021, eine dritte Injektion eines Coronavirus-Impfstoffs im Sheba Medical Center in Ramat Gan, Israel, erhalten hat. Pool Foto von Maya Alleruzzo/UPI Kredit: UPI/Alamy Live News

RM2RRDJD2–211229 -- RAMAT GAN, 29. Dezember 2021 -- eine israelische Frau erhält am 28. Dezember 2021 die vierte Dosis COVID-19-Impfstoff im Sheba Medical Center in der zentralisraelischen Stadt Ramat Gan. Israel begann am Montag mit Studien zu einer vierten Dosis Coronavirus-Impfstoff. /JINI über Xinhua ISRAEL-RAMAT GAN-COVID-19-4. DOSIS-IMPFSTOFF-STUDIE GideonxMarkowicz PUBLICATIONxNOTxINxCHN

RM2DPKJ2B–Ramat Gan, Israel. Dezember 2020. Der israelische Ministerpräsident Benjamin Netanjahu erhält am Samstag, den 19. Dezember 2020, im Sheba Medical Center in Ramat Gan, Israel, einen Coronavirus-Impfstoff (COVID-19). Pool Foto von Amir Cohen/UPI Kredit: UPI/Alamy Live News

RM2NFXKFF–Stella Stevens ist verstorben. BEVERLY HILLS, CA - DEZEMBER 7: Schauspielerin Stella Stevens besucht das Friends of Sheba Medical Center im 18. Sheba Humanitarian Award von Tel Hasomer Salute an Eduard Sarlui und Moshe Diamant am 7. Dezember 1988 im Beverly Hilton Hotel in Beverly Hills, Kalifornien Kredit: Ralph Dominguez/MediaPunch

RM3CWW88D–Ramat Gan, Israel. Oktober 2025. Eine der freigelassenen Geiseln, Bar Kupershtein, winkt aus einem Fahrzeug, als er im Sheba Medical Center ankommt. Quelle: Ilia Yefimovich/dpa/Alamy Live News

RM360°2A4DMM2–Eine Frau, die Geburt im Krankenhaus während der Nationalen Erdbeben Bohren. Mit Yitshak Kreiss MD im Hintergrund, Generaldirektor, Sheba Medical Center,

RM3A386J8–27. Juli 2014 - Ramat Gan, Israel - Banner, Zeichnungen und Segnungen schmücken den Eingang zum Sheba Medical Center und zeigen die Liebe und Unterstützung für IDF-Soldaten, die im Gazastreifen verletzt wurden. (Bild: © Nir Alon/ZUMA Wire)

RME5C9W2–Jerusalem, Israel. 27. Juli 2014. Banner, Zeichnungen und Segnungen schmücken den Eingang zu dem Sheba Medical Center, Liebe und Unterstützung für israelische Soldaten verletzt im Gaza-Streifen. Bildnachweis: Nir Alon/Alamy Live-Nachrichten

RME1MHWW–Israelische Ärzte transportieren US Armee Pfc. James Black, eine Mehrkanal-Radio Operator Betreuer zugewiesen der 44. Expeditionar

RMHEAC7C–Lital Dan, Top, ein Israel Defense Forces Medic gilt Make-up auf US Army Staff Sgt Willie Morgan, ein Generator-Mechaniker das 10. Armee Air and Missile Defense Command, während eine simulierte medizinische Evakuierung im Rahmen von Juniper Cobra 14 auf Hatzor Air Base, Israel, 20. Mai 2014 zugewiesen. Juniper-Cobra ist eine bilaterale computersimulierte Übung zur Verbesserung der Interoperabilität zwischen den U.S. European Command und Israel Defense Forces. Staff Sgt Joe W. McFadden

RMDN6EM1–13. September 2001 - Los Angeles, Kalifornien, USA - SUZANNE HUGHES. WOMEN OF ACHIEVEMENT AWARDS MITTAGESSEN. VON DEN FRAUEN DES SHEBA MEDICAL CENTER. FOUR SEASONS HOTEL, LOS ANGELES, CA 13. SEPTEMBER 2001. NINA PROMMER / 2001 K22841NP (Kredit-Bild: © Globe Photos/ZUMAPRESS.com)

RMJ0MY2W–Gäste besuchen die floralen inaugural Ball zugunsten Israels größtes Krankenhaus, Sheba Medical Center Featuring: Eve Where: London, Vereinigtes Königreich bei: 14. März 2017

RMH64RE3–Jason Alexander kommt an der Freunde des Sheba Medical Center 45. Jubiläums-Gala: zu Ehren unseres Helden im Beverly Wilshire Hotel in Beverly Hills, Kalifornien.

RM2DD8JYT–KEIN FILM, KEIN VIDEO, KEIN Fernsehen, KEINE DOKUMENTATION - Dr. Izzeldin Abuelaish nimmt am Sonntag, 18. Januar 2009, einen Anruf im Chaim Sheba Medical Center in Israel entgegen. Drei Töchter Abuelaischs wurden am Freitag durch einen israelischen Angriff im Gazastreifen getötet. Foto von Dion Nissenbaum/MCT/ABACAPRESS.COM

RMRPXJRD–BEVERLY HILLS, Ca - 26. Januar: Schauspielerin Anjelica Huston besucht die Freunde von Sheba Medical Center in Tel Hasomer's 15-04 Humanitarian Award Gruß zu Anjelica Huston am 26. Januar 1994 im Beverly Hilton Hotel in Beverly Hills, Kalifornien. Foto von Barry King/Alamy Stock Foto

RMB3CWXH–Embryologe an Embryonen durch Mikroskop an der Klinik in Sheba Medical Center in Tel Hashomer, Nachbarschaft in Ramat Gan, Israel

RMR7RK2A–Konfokales Mikroskop Bild eines Tissue-engineered microvessel vom menschlichen Gehirn mikrovaskuläre Endothelzellen in einem 3D-Matrix gebildet.

RMDPCN48–Sderot, Israel, 12. Januar 2014. Arbeiter bereiten das Grab für Ariel Sharon in Südisrael Havat Hashikmim, außen Sderot, am 12. Januar 2014. Der ehemalige israelische Ministerpräsident Ariel Scharon starb am Samstag im Alter von 85, der Direktor der Rehabilitationsklinik an der Sheba Medical Center, die Shlomo Noy auf einer Pressekonferenz im Krankenhaus bestätigt. (Xinhua)

RM2DTN7W2–London, Großbritannien. Dezember 2020. Ein israelischer Arzt bereitet am 19. Dezember 2020 im Sheba Medical Center in der zentralisraelischen Stadt Ramat Gan einen Impfstoff gegen das COVID-19-Virus vor. Kredit: Gil Cohen Magen/Xinhua/Alamy Live Nachrichten

RM2DPKJ2C–Ramat Gan, Israel. Dezember 2020. Der israelische Ministerpräsident Benjamin Netanjahu erhält am Samstag, den 19. Dezember 2020, im Sheba Medical Center in Ramat Gan, Israel, einen Coronavirus-Impfstoff (COVID-19). Pool Foto von Amir Cohen/UPI Kredit: UPI/Alamy Live News

RM2CDF6R2–Ramat Gan. August 2020. Ein israelischer Wissenschaftler führt am 27. August 2020 im Sheba Medical Center in der zentralisraelischen Stadt Ramat Gan einen sofortigen Detektionstest für COVID-19 durch. Kredit: Gil Cohen Magen/Xinhua/Alamy Live Nachrichten

RM2RRDJC6–211229 -- RAMAT GAN, 29. Dezember 2021 -- ein israelischer Mann erhält am 28. Dezember 2021 die vierte Dosis COVID-19-Impfstoff im Sheba Medical Center in der zentralisraelischen Stadt Ramat Gan. Israel begann am Montag mit Studien zu einer vierten Dosis Coronavirus-Impfstoff. Foto von /Xinhua ISRAEL-RAMAT GAN-COVID-19-4th DOSE-VACCINE-TRIAL GilxCohenxMagen PUBLICATIONxNOTxINxCHN

RM2NFXNHM–Stella Stevens ist verstorben. BEVERLY HILLS, CA - DEZEMBER 7: Schauspielerin Stella Stevens besucht das Friends of Sheba Medical Center im 18. Sheba Humanitarian Award von Tel Hasomer Salute an Eduard Sarlui und Moshe Diamant am 7. Dezember 1988 im Beverly Hilton Hotel in Beverly Hills, Kalifornien Kredit: Ralph Dominguez/MediaPunch

RM3CWW89N–Ramat Gan, Israel. Oktober 2025. Einer der freigelassenen Geiseln, Yossef Haim Ohana, sieht von einem Fahrzeug aus, als er im Sheba Medical Center ankommt. Quelle: Ilia Yefimovich/dpa/Alamy Live News

RM360°2A4DMMK–Eine Frau, die Geburt im Krankenhaus während der Nationalen Erdbeben Bohren. Mit Yitshak Kreiss MD im Hintergrund, Generaldirektor, Sheba Medical Center,

RM3A386J9–27. Juli 2014 - Ramat Gan, Israel - Banner, Zeichnungen und Segnungen schmücken den Eingang zum Sheba Medical Center und zeigen die Liebe und Unterstützung für IDF-Soldaten, die im Gazastreifen verletzt wurden. (Bild: © Nir Alon/ZUMA Wire)

RME5C9TW–Jerusalem, Israel. 27. Juli 2014. Banner, Zeichnungen und Segnungen schmücken den Eingang zu dem Sheba Medical Center, Liebe und Unterstützung für israelische Soldaten verletzt im Gaza-Streifen. Bildnachweis: Nir Alon/Alamy Live-Nachrichten

RMHEAC7D–Lital Dan, ein Israel Defense Forces Medic gilt Make-up auf das Gesicht des US Army Staff Sgt Willie Morgan, ein Generator-Mechaniker das 10. Armee Air and Missile Defense Command, während eine simulierte medizinische Evakuierung im Rahmen von Juniper Cobra 14 Hatzor Luftwaffenstützpunkt in Israel, 20. Mai 2014 zugewiesen. Juniper-Cobra ist eine bilaterale computersimulierte Übung zur Verbesserung der Interoperabilität zwischen den U.S. European Command und Israel Defense Forces. Staff Sgt Joe W. McFadden

RMDM9XN4–13. September 2001 - Los Angeles, Kalifornien, USA - CATHY GUISEWITE ist geehrt (Zeichner des "CATHY"). WOMEN OF ACHIEVEMENT AWARDS MITTAGESSEN. VON DEN FRAUEN DES SHEBA MEDICAL CENTER. FOUR SEASONS HOTEL, LOS ANGELES, CA 13. SEPTEMBER 2001. NINA PROMMER / 2001 K22841NP (Kredit-Bild: © Globe Photos/ZUMAPRESS.com)

RMJ0MY2A–Gäste besuchen die floralen inaugural Ball zugunsten Israels größtes Krankenhaus, Sheba Medical Center Featuring: Pandora wo: London, Vereinigtes Königreich bei: 14. März 2017

RMH64RD0–Lisa Daftari kommt an der Freunde des Sheba Medical Center 45. Jubiläums-Gala: zu Ehren unseres Helden im Beverly Wilshire Hotel in Beverly Hills, Kalifornien.

RM2DD8JWK–KEIN FILM, KEIN VIDEO, KEIN Fernsehen, KEIN DOKUMENTARFILM - Dr. Izzeldin Abuelaish steht über seiner Tochter Shata, die am Freitag durch einen israelischen Militärschlag in Gaza schwer verletzt wurde. Foto aufgenommen am Sonntag, 18. Januar 2009, im Chaim Sheba Medical Center in Israel, wo das Mädchen zur Behandlung aufgenommen wurde. Foto von Dion Nissenbaum/MCT/ABACAPRESS.COM

RMADBR3H–Embryologe an Embryonen durch Mikroskop an der Klinik in Sheba Medical Center in Tel Hashomer, Nachbarschaft in Ramat Gan, Israel

RMRPXJRF–BEVERLY HILLS, Ca - 26. Januar: Schauspielerin Anjelica Huston besucht die Freunde von Sheba Medical Center in Tel Hasomer's 15-04 Humanitarian Award Gruß zu Anjelica Huston am 26. Januar 1994 im Beverly Hilton Hotel in Beverly Hills, Kalifornien. Foto von Barry King/Alamy Stock Foto

RM2DPKJ2D–Ramat Gan, Israel. Dezember 2020. Der israelische Ministerpräsident Benjamin Netanjahu erhält am Samstag, den 19. Dezember 2020, im Sheba Medical Center in Ramat Gan, Israel, einen Coronavirus-Impfstoff (COVID-19). Pool Foto von Amir Cohen/UPI Kredit: UPI/Alamy Live News

RM2CDF6R3–Ramat Gan. August 2020. Ein israelischer Wissenschaftler führt am 27. August 2020 im Sheba Medical Center in der zentralisraelischen Stadt Ramat Gan einen sofortigen Detektionstest für COVID-19 durch. Kredit: Gil Cohen Magen/Xinhua/Alamy Live Nachrichten

RM2RRDJCM–211229 -- RAMAT GAN, 29. Dezember 2021 -- ein israelischer Mann erhält am 28. Dezember 2021 die vierte Dosis COVID-19-Impfstoff im Sheba Medical Center in der zentralisraelischen Stadt Ramat Gan. Israel begann am Montag mit Studien zu einer vierten Dosis Coronavirus-Impfstoff. /JINI über Xinhua ISRAEL-RAMAT GAN-COVID-19-4. DOSIS-IMPFSTOFF-STUDIE GideonxMarkowicz PUBLICATIONxNOTxINxCHN

RM2NFXNJP–Stella Stevens ist verstorben. BEVERLY HILLS, CA - DEZEMBER 7: Schauspielerin Stella Stevens besucht das Friends of Sheba Medical Center im 18. Sheba Humanitarian Award von Tel Hasomer Salute an Eduard Sarlui und Moshe Diamant am 7. Dezember 1988 im Beverly Hilton Hotel in Beverly Hills, Kalifornien Kredit: Ralph Dominguez/MediaPunch

RM2RR52G3–201219 -- RAMAT GAN ISRAEL, 19. Dezember 2020 -- der israelische Premierminister Benjamin Netanyahu spricht, nachdem er am 19. Dezember 2020 im Sheba Medical Center in der zentralisraelischen Stadt Ramat Gan einen Impfstoff erhalten hatte. Netanjahu wurde am Samstagabend in einer Live-Fernsehsendung gegen das COVID-19-Virus geimpft. Foto von /Xinhua ISRAEL-RAMAT GAN-PM-COVID-19-VACCINATION GilxCohenxMagen PUBLICATIONxNOTxINxCHN

RM3CWW89H–Ramat Gan, Israel. Oktober 2025. Einer der freigelassenen Geiseln, Yossef Haim Ohana, winkt aus einem Fahrzeug, als er im Sheba Medical Center ankommt. Quelle: Ilia Yefimovich/dpa/Alamy Live News

RM360°2A4DMM9–Eine Frau, die Geburt im Krankenhaus während der Nationalen Erdbeben Bohren. Mit Yitshak Kreiss MD im Hintergrund, Generaldirektor, Sheba Medical Center,

RM3A386J3–27. Juli 2014 - Ramat Gan, Israel - Banner, Zeichnungen und Segnungen schmücken den Eingang zum Sheba Medical Center und zeigen die Liebe und Unterstützung für IDF-Soldaten, die im Gazastreifen verletzt wurden. (Bild: © Nir Alon/ZUMA Wire)

RME5C9TF–Jerusalem, Israel. 27. Juli 2014. Banner, Zeichnungen und Segnungen schmücken den Eingang zu dem Sheba Medical Center, Liebe und Unterstützung für israelische Soldaten verletzt im Gaza-Streifen. Bildnachweis: Nir Alon/Alamy Live-Nachrichten

RM3AK0K7G–Woman of Achievement Award Luncheon von Friends of Sheba Medical Center im Beverly Hills Hotel in Beverly Hills, CA. 10-15-2009 2009...... KATHY IRLAND. K63424SK (Bild: © Scott Kirkland/Globe Photos/ZUMAPRESS.com)

RMHEAC7N–US-Militärangehörige und israelischen Mediziner posieren für ein Foto vor ein Flugzeug der US Air Force c-17 Globemaster III und zwei israelischen Krankenwagen nach eine simulierte medizinische Evakuierung auf dem Flug Linie am internationalen Flughafen Ben Gurion in Tel Aviv, Israel, 20. Mai 2014, während Juniper Cobra 14. Juniper-Cobra ist eine bilaterale computersimulierte Übung zur Verbesserung der Interoperabilität zwischen den U.S. European Command und israelische Verteidigung-Kräfte. Staff Sgt Joe W. McFadden

RMDM9XN5–13. September 2001 - Los Angeles, Kalifornien, USA - CATHY GUISEWITE ist geehrt (Zeichner des "CATHY"). WOMEN OF ACHIEVEMENT AWARDS MITTAGESSEN. VON DEN FRAUEN DES SHEBA MEDICAL CENTER. FOUR SEASONS HOTEL, LOS ANGELES, CA 13. SEPTEMBER 2001. NINA PROMMER / 2001 K22841NP (Kredit-Bild: © Globe Photos/ZUMAPRESS.com)

RMJ0MY2T–Gäste besuchen die floralen inaugural Ball zugunsten Israels größtes Krankenhaus, Sheba Medical Center Featuring: Eve Where: London, Vereinigtes Königreich bei: 14. März 2017

RMAD7M5G–Embryologe an Embryonen durch Mikroskop an der Klinik in Sheba Medical Center in Tel Hashomer, Nachbarschaft in Ramat Gan, Israel

RMH64RDM–Jason Alexander kommt an der Freunde des Sheba Medical Center 45. Jubiläums-Gala: zu Ehren unseres Helden im Beverly Wilshire Hotel in Beverly Hills, Kalifornien.

RMRPXJPK–BEVERLY HILLS, Ca - 26. Januar: Schauspielerin Anjelica Huston besucht die Freunde von Sheba Medical Center in Tel Hasomer's 15-04 Humanitarian Award Gruß zu Anjelica Huston am 26. Januar 1994 im Beverly Hilton Hotel in Beverly Hills, Kalifornien. Foto von Barry King/Alamy Stock Foto

RM2DPKJ29–Ramat Gan, Israel. Dezember 2020. Der israelische Ministerpräsident Benjamin Netanjahu erhält am Samstag, den 19. Dezember 2020, im Sheba Medical Center in Ramat Gan, Israel, einen Coronavirus-Impfstoff (COVID-19). Pool Foto von Amir Cohen/UPI Kredit: UPI/Alamy Live News

RM2CDF6RX–Ramat Gan. August 2020. Ein israelischer Wissenschaftler führt am 27. August 2020 im Sheba Medical Center in der zentralisraelischen Stadt Ramat Gan einen sofortigen Detektionstest für COVID-19 durch. Kredit: Gil Cohen Magen/Xinhua/Alamy Live Nachrichten

RM2D8PFG2–Peking, China. Oktober 2020. Ein israelischer medizinischer Clown stutzt, bevor sie am 20. Oktober 2020 die COVID-19 Abteilung des Sheba Medical Centers besucht, um den Patienten in der zentralisraelischen Stadt Ramat Gan Glück zu bringen. Kredit: Gil Cohen Magen/Xinhua/Alamy Live Nachrichten

RM2RR52FK–201219 -- RAMAT GAN ISRAEL, 19. Dezember 2020 -- der israelische Premierminister Benjamin Netanyahu spricht, nachdem er am 19. Dezember 2020 im Sheba Medical Center in der zentralisraelischen Stadt Ramat Gan einen Impfstoff erhalten hatte. Netanjahu wurde am Samstagabend in einer Live-Fernsehsendung gegen das COVID-19-Virus geimpft. Foto von /Xinhua ISRAEL-RAMAT GAN-PM-COVID-19-VACCINATION GilxCohenxMagen PUBLICATIONxNOTxINxCHN

RMDPB9R7–(140111)--Peking, 11. Januar 2014 (Xinhua)--A Patient ruht in der Lobby der Chaim Sheba Medical Center in Tel Hashomer, wo Ariel Sharon, in der Nähe von Tel Aviv, Israel, am 10. Januar 2014 ins Krankenhaus eingeliefert. Israels Ex-Premier Ariel Sharon stirbt bei 85 am Samstag. (Xinhua/Li Rui) (Djj)

RM2RRAGN7–210730 -- RAMAT GAN ISRAEL, 30. Juli 2021 -- israelischer Präsident Isaac Herzog L, Front erhält am 30. Juli 2021 die dritte Dosis des COVID-19-Impfstoffs im Sheba Medical Center in Ramat Gan, Zentralisrael. Isaac Herzog erhielt am Freitag den dritten Pfizer-BioNTech Jab. Via Xinhua ISRAEL-RAMAT GAN-PRESIDENT-COVID-19-VACCINE-THIRD DOSE YonatanxSindel/JINI PUBLICATIONxNOTxINxCHN

RM3CWX449–Ramat Gan, Israel. Oktober 2025. Die israelische Geisel Segev Kalfon, der während des Angriffs der Hamas am 7. Oktober 2023 entführt und nach Gaza gebracht wurde, erreichte das Sheba Medical Center, während eines Waffenstillstands zwischen Israel und Hamas. Quelle: Ilia Yefimovich/dpa/Alamy Live News

RM2RR59YA–201229 -- RAMAT GAN, 29. Dezember 2020 -- Ein Freiwilliger erhält den von Israel entwickelten Anti-Coronavirus-Impfstoff im Sheba Medical Center in der zentralisraelischen Stadt Ramat Gan, 28. Dezember 2020. Die zweite Phase der klinischen Studie für den COVID-19-Impfstoffkandidaten, die vom staatlichen Institut für biologische Forschung Israels entwickelt wurde, wurde am Montag durchgeführt. Foto von /Xinhua ISRAEL-RAMAT GAN-COVID-19-VACCINE GilxCohenxMagen PUBLICATIONxNOTxINxCHN

RM360°2A4DMFE–Ein verletzter Mann im Lazarett während des Nationalen Erdbeben Bohren hospitalisiert. Sheba Medical Center, Tel Hashomer, Israel. 25 Sep, 2019. 360 Foto vr

RM3AK0K80–Woman of Achievement Award Luncheon von Friends of Sheba Medical Center im Beverly Hills Hotel in Beverly Hills, CA. 10-15-2009 2009...... KATHY IRLAND. K63424SK (Bild: © Scott Kirkland/Globe Photos/ZUMAPRESS.com)

RME5C9DG–Jerusalem, Israel. 27. Juli 2014. 29 IDF Soldaten sind derzeit in das Sheba Medical Center behandelt, nach Verletzungen im Gaza-Streifen neben 50 palästinensische Kinder, von denen die meisten wegen Krebs im gleichen israelischen Krankenhaus behandelt werden. Bildnachweis: Nir Alon/Alamy Live-Nachrichten

RMHEAC7E–US Army Pfc. Jessica Galindo, Recht, Generator Mechaniker zugewiesen 317th Unterhaltsbetrieb überprüft auf Staff Sgt Willie Morgan, ein Generator-Mechaniker das 10. Armee Air and Missile Defense Command, während eine simulierte medizinische Evakuierung im Rahmen von Juniper Cobra 14 Hatzor Luftwaffenstützpunkt in Israel, 20. Mai 2014 zugewiesen. Juniper-Cobra ist eine bilaterale computersimulierte Übung zur Verbesserung der Interoperabilität zwischen den U.S. European Command und Israel Defense Forces. Staff Sgt Joe W. McFadden

RMB3CTAC–Embryologe an Embryonen durch Mikroskop an der Klinik in Sheba Medical Center in Tel Hashomer, Nachbarschaft in Ramat Gan, Israel

RMDM9XN3–13. September 2001 - Los Angeles, Kalifornien, USA - CATHY GUISEWITE ist geehrt (Zeichner des "CATHY"). WOMEN OF ACHIEVEMENT AWARDS MITTAGESSEN. VON DEN FRAUEN DES SHEBA MEDICAL CENTER. FOUR SEASONS HOTEL, LOS ANGELES, CA 13. SEPTEMBER 2001. NINA PROMMER / 2001 K22841NP (Kredit-Bild: © Globe Photos/ZUMAPRESS.com)

RMJ0MY29–Gäste besuchen die floralen inaugural Ball zugunsten Israels größtes Krankenhaus, Sheba Medical Center Featuring: Pandora wo: London, Vereinigtes Königreich bei: 14. März 2017

RMH64REJ–Jason Alexander kommt an der Freunde des Sheba Medical Center 45. Jubiläums-Gala: zu Ehren unseres Helden im Beverly Wilshire Hotel in Beverly Hills, Kalifornien.

RMRPXJRE–BEVERLY HILLS, Ca - 26. Januar: Schauspielerin Anjelica Huston besucht die Freunde von Sheba Medical Center in Tel Hasomer's 15-04 Humanitarian Award Gruß zu Anjelica Huston am 26. Januar 1994 im Beverly Hilton Hotel in Beverly Hills, Kalifornien. Foto von Barry King/Alamy Stock Foto

RM2DPKJ2G–Ramat Gan, Israel. Dezember 2020. Der israelische Ministerpräsident Benjamin Netanjahu wartet darauf, am Samstag, den 19. Dezember 2020, im Sheba Medical Center in Ramat Gan, Israel, einen Coronavirus-Impfstoff (COVID-19) zu erhalten. Pool Foto von Amir Cohen/UPI Kredit: UPI/Alamy Live News

RM2GACND1–Ramat Gan, Israel. Juli 2021. Der israelische Präsident Isaac Herzog erhält am Freitag, den 30. Juli 2021, eine dritte Injektion eines Coronavirus-Impfstoffs, während seine Frau Michal, die sich nach links aufmachte, im Sheba Medical Center in Ramat Gan, Israel, reagiert. Pool Foto von Maya Alleruzzo/UPI Kredit: UPI/Alamy Live News

RM2DPKJ2J–Ramat Gan, Israel. Dezember 2020. Der israelische Ministerpräsident Benjamin Netanjahu schaut zu, bevor er am Samstag, den 19. Dezember 2020, im Sheba Medical Center in Ramat Gan, Israel, einen Coronavirus-Impfstoff (COVID-19) erhält. Pool Foto von Amir Cohen/UPI Kredit: UPI/Alamy Live News

RMDPB9R8–(140111)--Peking, 11. Januar 2014 (Xinhua)--A Mann geht von der Chaim Sheba Medical Center in Tel Hashomer, wo Ariel Sharon, in der Nähe von Tel Aviv, Israel, am 10. Januar 2014 ins Krankenhaus eingeliefert. Israels Ex-Premier Ariel Sharon stirbt bei 85 am Samstag. (Xinhua/Li Rui) (Djj)

RM2HCFXY4–(211229) -- RAMAT GAN, 29. Dezember 2021 (Xinhua) -- eine israelische Frau erhält am 28. Dezember 2021 die vierte Dosis des COVID-19-Impfstoffs im Sheba Medical Center in der zentralisraelischen Stadt Ramat Gan. Israel begann am Montag mit der Prüfung einer vierten Dosis Coronavirus-Impfstoff. (Gideon Markowicz/JINI über Xinhua)

RM2RR59XM–201229 -- RAMAT GAN, 29. Dezember 2020 -- Ein Freiwilliger erhält den von Israel entwickelten Anti-Coronavirus-Impfstoff im Sheba Medical Center in der zentralisraelischen Stadt Ramat Gan, 28. Dezember 2020. Die zweite Phase der klinischen Studie für den COVID-19-Impfstoffkandidaten, die vom staatlichen Institut für biologische Forschung Israels entwickelt wurde, wurde am Montag durchgeführt. Foto von /Xinhua ISRAEL-RAMAT GAN-COVID-19-VACCINE GilxCohenxMagen PUBLICATIONxNOTxINxCHN

RM3CWX44A–Ramat Gan, Israel. Oktober 2025. Die israelische Geisel Segev Kalfon, der während des Angriffs der Hamas am 7. Oktober 2023 entführt und nach Gaza gebracht wurde, erreichte das Sheba Medical Center, während eines Waffenstillstands zwischen Israel und Hamas. Quelle: Ilia Yefimovich/dpa/Alamy Live News

RM360°2A4DMWH–Ein frühgeborenes Baby inside Neugeborenen neugeborene Inkubator während der Nationalen Erdbeben Bohren geboren in Feldlazarett in Sheba Medical Center, Tel Hashomer, Israe

RM3AK0K7H–Woman of Achievement Award Luncheon von Friends of Sheba Medical Center im Beverly Hills Hotel in Beverly Hills, CA. 10-15-2009 2009...... KATHY IRLAND. K63424SK (Bild: © Scott Kirkland/Globe Photos/ZUMAPRESS.com)

RME5C9DW–Jerusalem, Israel. 27. Juli 2014. 29 IDF Soldaten sind derzeit in das Sheba Medical Center behandelt, nach Verletzungen im Gaza-Streifen neben 50 palästinensische Kinder, von denen die meisten wegen Krebs im gleichen israelischen Krankenhaus behandelt werden. Bildnachweis: Nir Alon/Alamy Live-Nachrichten
RMB8TK0J–Embryologe Inverkehrbringen Embryo auf einer Kulturschale während der vitrifikation Prozess an der Klinik in Sheba Medical Center in Tel Hashomer, Israel

RMHEAC7G–Israel Defense Forces Sanitäter und US Army Medic, oben links, die simulierten Wunden auf US Army Staff Sgt Willie Morgan behandeln, ein Generator-Mechaniker zugewiesen das 10. Armee Air and Missile Defense Command, während eine simulierte medizinische Evakuierung im Rahmen von Juniper Cobra 14 auf Hatzor Air Base, Israel, 20. Mai 2014. Juniper-Cobra ist eine bilaterale computersimulierte Übung zur Verbesserung der Interoperabilität zwischen den U.S. European Command und Israel Defense Forces. Staff Sgt Joe W. McFadden

RMJ0MY2B–Gäste besuchen die floralen inaugural Ball zugunsten Israels größtes Krankenhaus, Sheba Medical Center Featuring: Nicola Hughes wo: London, Vereinigtes Königreich bei: 14. März 2017

RMH64REY–Moran Atias kommt an der Freunde des Sheba Medical Center 45. Jubiläums-Gala: zu Ehren unseres Helden im Beverly Wilshire Hotel in Beverly Hills, Kalifornien.

RMRPXJPY–BEVERLY HILLS, Ca - 26. Januar: Schauspielerin Kate Linder besucht die Freunde von Sheba Medical Center in Tel Hasomer's 15-04 Humanitarian Award Gruß zu Anjelica Huston am 26. Januar 1994 im Beverly Hilton Hotel in Beverly Hills, Kalifornien. Foto von Barry King/Alamy Stock Foto

RMMPMTDR–Konfokales Mikroskop Bild eines Tissue-engineered microvessel vom menschlichen Gehirn mikrovaskuläre Endothelzellen in einem 3D-Matrix gebildet. Bild mit freundlicher Genehmigung von Prof. Peter Searson, Johns Hopkins University.

RM2DPKJ2E–Ramat Gan, Israel. Dezember 2020. Der israelische Ministerpräsident Benjamin Netanjahu spricht vor der Verabreichung eines Coronavirus-Impfstoffs (COVID-19) im Sheba Medical Center in Ramat Gan, Israel, am Samstag, den 19. Dezember 2020, zu den Medien. Pool Foto von Amir Cohen/UPI Kredit: UPI/Alamy Live News

RM2GACNBH–Ramat Gan, Israel. Juli 2021. Der israelische Präsident Isaac Herzog spricht mit seiner Frau Michal, der gegangen ist, bevor das Paar am Freitag, den 30. Juli 2021, eine dritte Injektion mit Coronavirus-Impfstoff im Sheba Medical Center in Ramat Gan, Israel, erhielt. Pool Foto von Maya Alleruzzo/UPI Kredit: UPI/Alamy Live News

RM2HCFXXH–(211229) -- RAMAT GAN, 29. Dezember 2021 (Xinhua) -- ein israelischer Mann erhält am 28. Dezember 2021 die vierte Dosis des COVID-19-Impfstoffs im Sheba Medical Center in der zentralisraelischen Stadt Ramat Gan. Israel begann am Montag mit der Prüfung einer vierten Dosis Coronavirus-Impfstoff. (Gideon Markowicz/JINI über Xinhua)

RM2RR59XK–201229 -- RAMAT GAN, 29. Dezember 2020 -- Ein Freiwilliger erhält den von Israel entwickelten Anti-Coronavirus-Impfstoff im Sheba Medical Center in der zentralisraelischen Stadt Ramat Gan, 28. Dezember 2020. Die zweite Phase der klinischen Studie für den COVID-19-Impfstoffkandidaten, die vom staatlichen Institut für biologische Forschung Israels entwickelt wurde, wurde am Montag durchgeführt. Foto von /Xinhua ISRAEL-RAMAT GAN-COVID-19-VACCINE GilxCohenxMagen PUBLICATIONxNOTxINxCHN

RM3CWWP82–Ramat Gan, Israel. Oktober 2025. Israelische Freigelassene Geiseln Ariel Cunio und seine Freundin Arbel Yahud, die während des Angriffs der Hamas am 7. Oktober 2023 entführt und nach Gaza gebracht wurden, treffen im Sheba Medical Center ein, während eines Waffenstillstands zwischen Israel und Hamas. Quelle: Ilia Yefimovich/dpa/Alamy Live News

RM2RRAGP7–210730 -- RAMAT GAN ISRAEL, 30. Juli 2021 -- israelischer Präsident Isaac Herzog L, Front berührt Ellbogen mit dem israelischen Premierminister Naftali Bennett R, Front im Sheba Medical Center in Ramat Gan, Zentralisrael, am 30. Juli 2021. Isaac Herzog erhielt am Freitag den dritten Pfizer-BioNTech Jab. Via Xinhua ISRAEL-RAMAT GAN-PRESIDENT-COVID-19-VACCINE-THIRD DOSE YonatanxSindel/JINI PUBLICATIONxNOTxINxCHN

RM360°2A4DMKR–Eine Frau im Krankenhaus während der Nationalen Erdbeben Bohren hospitalisiert. Sheba Medical Center, Tel Hashomer, Israel, 25 Sep, 2019. 360 Foto vr panora

RM2RR59XX–201229 -- RAMAT GAN, 29. Dezember 2020 -- Ein Freiwilliger erhält einen medizinischen Test, bevor er den von Israel entwickelten Anti-Coronavirus-Impfstoff im Sheba Medical Center in der zentralen israelischen Stadt Ramat Gan, 28. Dezember 2020 erhält. Die zweite Phase der klinischen Studie für den COVID-19-Impfstoffkandidaten, die vom staatlichen Institut für biologische Forschung Israels entwickelt wurde, wurde am Montag durchgeführt. Foto von /Xinhua ISRAEL-RAMAT GAN-COVID-19-VACCINE GilxCohenxMagen PUBLICATIONxNOTxINxCHN

RMBD312A–Embryologe Inverkehrbringen Embryo auf einer Kulturschale während der vitrifikation Prozess an der Klinik in Sheba Medical Center in Tel Hashomer, Israel

RM3AK0K7C–Woman of Achievement Award Luncheon von Friends of Sheba Medical Center im Beverly Hills Hotel in Beverly Hills, CA. 10-15-2009 2009...... KATHY IRLAND. K63424SK (Bild: © Scott Kirkland/Globe Photos/ZUMAPRESS.com)

RME5C9D6–Jerusalem, Israel. 27. Juli 2014. 29 IDF Soldaten sind derzeit in das Sheba Medical Center behandelt, nach Verletzungen im Gaza-Streifen neben 50 palästinensische Kinder, von denen die meisten wegen Krebs im gleichen israelischen Krankenhaus behandelt werden. Bildnachweis: Nir Alon/Alamy Live-Nachrichten


